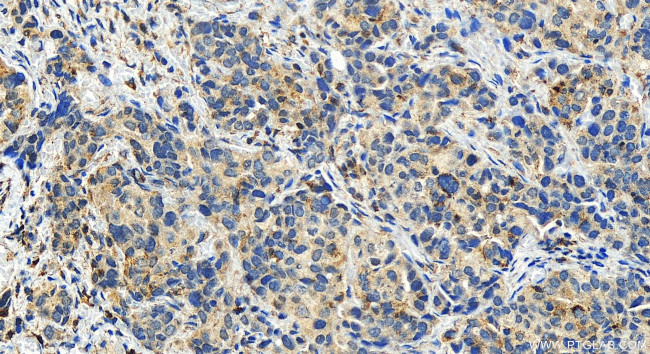
LACC1 Antibody in Immunohistochemistry (Paraffin) (IHC (P))

Search
Proteintech
LACC1 Polyclonal Antibody
{{$productOrderCtrl.translations['antibody.pdp.commerceCard.promotion.promotions']}}
{{$productOrderCtrl.translations['antibody.pdp.commerceCard.promotion.viewpromo']}}
{{$productOrderCtrl.translations['antibody.pdp.commerceCard.promotion.promocode']}}: {{promo.promoCode}} {{promo.promoTitle}} {{promo.promoDescription}}. {{$productOrderCtrl.translations['antibody.pdp.commerceCard.promotion.learnmore']}}
产品信息
27895-1-AP
种属反应
宿主/亚型
分类
类型
抗原
偶联物
形式
浓度
规格
纯化类型
保存液
内含物
保存条件
运输条件
产品详细信息
Immunogen sequence: NISYERDGEQ DNCEIETSNG LSALLEEFEI VSCPSMAATL YTIKQKIDEK NLSSIKVIVP RHRKTLMKAF IDQLFTDVYN FEFEDLQVTF RGGLFKQSIE INVITAQELR GIQNEIETFL RSLPALRGKL TIITSSLIPD IFIHGFTTRT GGISYIPTLS SFNLFSSSKR RDPKVVVQEN LRRLANAAGF NVEKFYRIKT HHSNDIWIMG RKEPDSYDG
靶标信息
This gene encodes an oxidoreductase that promotes fatty-acid oxidation, with concomitant inflammasome activation, mitochondrial and NADPH-oxidase-dependent reactive oxygen species production, and bactericidal activity of macrophages. The encoded protein forms a complex with fatty acid synthase on peroxisomes and is thought to be modulated by peroxisome proliferator-activated receptor signaling events. Naturally occurring mutations in this gene are associated with inflammatory bowel disease, Behcet's disease, leprosy, ulcerative colitis, early-onset Crohn's disease, and systemic juvenile idiopathic arthritis.
仅用于科研。不用于诊断过程。未经明确授权不得转售。
篇参考文献 (0)
生物信息学
蛋白别名: Adenosine deaminase LACC1; Fatty acid metabolism-immunity nexus; Guanosine phosphorylase LACC1; Isocyanic acid synthase; laccase (multicopper oxidoreductase) domain containing 1; Laccase domain-containing protein 1; Purine nucleoside phosphorylase LACC1; S-methyl-5'-thioadenosine phosphorylase LACC1; unnamed protein product
基因别名: 9030625A04Rik; C13orf31; FAMIN; JUVAR; LACC1
UniProt ID: (Human) Q8IV20, (Mouse) Q8BZT9
Entrez Gene ID: (Human) 144811, (Mouse) 210808